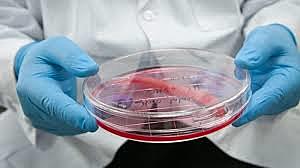
ÓRGANOS CREADOS EN LABORATORIO

-
El hombre utilizo piezas de madera para poder inmovilizar los miembros de aquellos que habían sufrido algún accidente
-
En esa época los curanderos aplicaban aceites e ungüentos a aquellas personas que padecían alguna enfermedad
-
Se diseccionan por primera vez cadáveres humanos para analizarlos, con lo cual se obtiene información más detallada sobre la anatomía del cuerpo humano
-
William Harvey descubre que la sangre es un líquido que circula a través del cuerpo humano. También se descubre que el corazón es el órgano encargado de hacer que esta circulación se desarrolle.
-
En pleno asedio de la viruela Edward Jenner, se percató de que las campesinas que ordeñaban vacas nunca la padecían porque estaban inmunizadas gracias a un virus parecido, la viruela de las vacas, que sólo se daba en estos animales y era mucho más benigna que la humana. Tras mucho estudio, supuso la que se considera la primera vacuna de la Historia.
-
Humphry Davy anuncia las propiedades anestésicas del óxido nitroso, posteriormente desarrollado hasta la anestesia que es utilizada hoy en día.
-
Louis Pasteur descubre que ciertos microbios son agentes causantes de enfermedades. Es por esto que Pasteur formula la teoría de los gérmenes, en la que se explica que las bacterias son las causantes de las enfermedades
-
René Laennec inventa el estetoscopio, artilugio médico utilizado para medir los sonidos cardíacos y respiratorios
-
El físico Wilhelm Konrad, descubrió accidentalmente la existencia de los Rayos - X, mientras intentaba descubrir la luz fluorescente
-
La penicilina fue el primer antibiótico empleado ampliamente en medicina. Su descubrimiento ha sido atribuido a Alexander Fleming en 1928, lo que le hizo obtener el Premio Nobel
-
VIH (virus de inmunodeficiencia humana). El descubrimiento del virus permitió el desarrollo de un anticuerpo, el cual se comenzó a utilizar para identificar dentro de los grupos de riesgo a los infectados.
-
La oveja Dolly fue el primer mamífero en ser clonado de una célula adulta
-
El uso de diminutos robots para la cura de enfermedades, y en concreto para luchar contra el cáncer estando dentro del cuerpo, es uno de los usos más significativos de esta tecnología.
-
Esta tecnología permitirá en el futuro remplazar órganos en caso de enfermedades como el cáncer, sin la necesidad de esperar un donador y cambiando para siempre la manera en la que afrontamos este y otros problemas de salud.
-
Dos grupos de científicos ayudaron a personas paralizadas a caminar otra vez, estimulando su médula espinal con impulsos eléctricos.
-
Científicos hicieron avances notables para curar la principal causa de ceguera en el mundo: la degeneración macular asociada a la edad, también llamada maculopatía.
Want to make a timeline like this?
Use Timetoast to turn dates, events, milestones, and phases into a clear visual timeline you can build and share. Timetoast is a timeline maker for work, school, research, and stories.